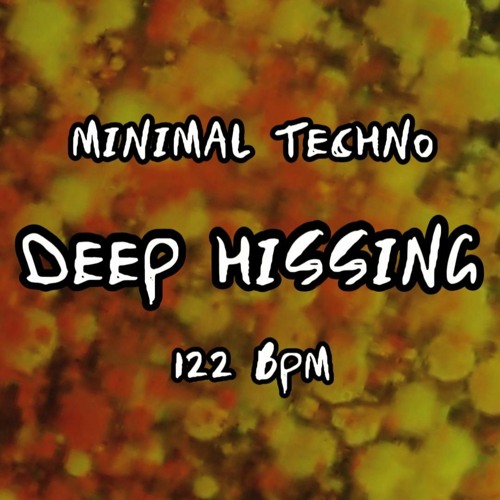
Deep Hissing

Deep Hissing
ExperiFrequency
7
1:01
Dec 9, 2023
2
1
Trackname: DEEP HISSING - 122BPM
Genre: Minimal Techno
Artist: ExperiFrequency
Coming soon...
Follow my other channels if you like my work.
Twitter: twitter.com/expfreq
Youtube: www.youtube.com/channel/UCEHGfocw…






